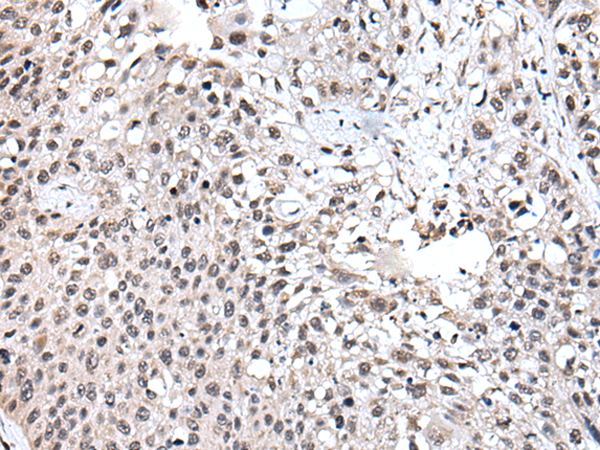

中文名稱: 兔抗UBE2E3多克隆抗體
|
Background: |
The modification of proteins with ubiquitin is an important cellular mechanism for targeting abnormal or short-lived proteins for degradation. Ubiquitination involves at least three classes of enzymes: ubiquitin-activating enzymes, or E1s, ubiquitin-conjugating enzymes, or E2s, and ubiquitin-protein ligases, or E3s. This gene encodes a member of the E2 ubiquitin-conjugating enzyme family. The encoded protein shares 100% sequence identity with the mouse and rat counterparts, which indicates that this enzyme is highly conserved in eukaryotes. Multiple alternatively spliced transcript variants encoding the same protein have been found for this gene. |
|
Applications: |
ELISA, IHC |
|
Name of antibody: |
UBE2E3 |
|
Immunogen: |
Fusion protein of human UBE2E3 |
|
Full name: |
ubiquitin conjugating enzyme E2E 3 |
|
Synonyms: |
UBCH9; UbcM2 |
|
SwissProt: |
Q969T4 |
|
ELISA Recommended dilution: |
5000-10000 |
|
IHC positive control: |
Human lung cancer and human esophagus cancer |
|
IHC Recommend dilution: |
30-150 |
購物車
幫助
021-54845833/15800441009
